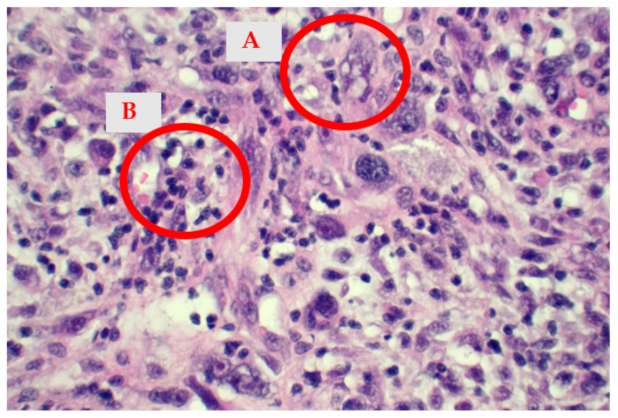

A Rare Case of Undifferentiated Pleomorphic Cardiac Sarcoma with Inflammatory Pattern
Abstract
:1. Background
2. Case Report
2.1. Patient Information
2.2. Preoperative Findings
2.3. Intraoperative Findings
2.4. Histological Findings
2.5. Postoperative Evolution
3. Discussion
4. Conclusions
Author Contributions
Funding
Institutional Review Board Statement
Informed Consent Statement
Data Availability Statement
Conflicts of Interest
References
- Vallés-Torres, J.; Izquierdo-Villarroya, M.B.; Vallejo-Gil, J.M.; Casado-Domínguez, J.M.; Roche Latasa, A.B.; Auquilla-Clavijo, P. Cardiac Undifferentiated Pleomorphic Sarcoma Mimicking Left Atrial Myxoma. J. Cardiothorac. Vasc. Anesth. 2018, 33, 493–496. [Google Scholar] [CrossRef] [PubMed]
- Yanagisawa, R.; Nakamura, T.; Ogiso, Y.; Hachiya, A.; Fujihara, I.; Morita, D.; Kazuo, S.; Kitamura, M.; Matsui, H.; Nishihima, F.; et al. Interleukin-8-producing primary cardiac undifferentiated sarcoma in a child with sustained fever. Pediatr. Int. 2015, 57, 742–745. [Google Scholar] [CrossRef] [PubMed]
- Watson, R.; Frye, J.; Trieu, M.; Yang, M.X. Primary Undifferentiated Pleomorphic Cardiac Sarcoma with MDM2 Amplification Presenting as Acute Left-Sided Heart Failure. BMJ Case Rep. 2018, 2018, bcr-2018-226073. [Google Scholar] [CrossRef] [PubMed]
- Burke, A.; Jeudy, J.; Virmani, R. Cardiac Tumours: An Update: Cardiac Tumours. Heart 2008, 94, 117–123. [Google Scholar] [CrossRef]
- Centofanti, P.; Di Rosa, E.; Deorsola, L.; Dato, G.M.; Patanè, F.; La Torre, M.; Barbato, L.; Verzini, A.; Fortunato, G.; di Summa, M. Primary Cardiac Tumors: Early and Late Results of Surgical Treatment in 91 Patients. Ann. Thorac. Surg. 1999, 68, 1236–1241. [Google Scholar] [CrossRef]
- Wang, J.; Dong, S.; Zhang, J.; Gao, S.; Li, Z.; Li, P.; Yuan, J.; Tian, Z. Undifferentiated Pleomorphic Sarcoma with Neoplastic Fever: A Retrospective Study. Cancer Manag. Res. 2021, 13, 8481–8487. [Google Scholar] [CrossRef]
- Zell, J.A.; Chang, J.C. Neoplastic Fever: A Neglected Paraneoplastic Syndrome. Support Care Cancer 2005, 13, 870–877. [Google Scholar] [CrossRef]
- Sørensen, H.T.; Mellemkjaer, L.; Skriver, M.V.; Johnsen, S.P.; Nørgård, B.; Olsen, J.H.; Baron, J.A. Fever of Unknown Origin and Cancer: A Population-Based Study. Lancet Oncol. 2005, 6, 851–855. [Google Scholar] [CrossRef]
- Hudzik, B.; Miszalski-Jamka, K.; Glowacki, J.; Lekston, A.; Gierlotka, M.; Zembala, M.; Polonski, L.; Gasior, M. Malignant Tumors of the Heart. Cancer Epidemiol. 2015, 39, 665–672. [Google Scholar] [CrossRef]
- Burke, A.P.; Cowan, D.; Virmani, R. Primary Sarcomas of the Heart. Cancer 1992, 69, 387–395. [Google Scholar] [CrossRef]
- Truong, P.T.; Jones, S.O.; Martens, B.; Alexander, C.; Paquette, M.; Joe, H.; Hart, J.; Allan, S.J. Treatment and Outcomes in Adult Patients with Primary Cardiac Sarcoma: The British Columbia Cancer Agency Experience. Ann. Surg. Oncol. 2009, 16, 3358–3365. [Google Scholar] [CrossRef]
- Chan, J.Y.; Zhang, Z.; Chew, W.; Tan, G.F.; Lim, C.L.; Zhou, L.; Goh, W.L.; Poon, E.; Somasundaram, N.; Selvarajan, S.; et al. Biological Significance and Prognostic Relevance of Peripheral Blood Neutrophil-to-Lymphocyte Ratio in Soft Tissue Sarcoma. Sci. Rep. 2018, 8, 11959. [Google Scholar] [CrossRef] [Green Version]
- Karakiewicz, P.I.; Hutterer, G.C.; Trinh, Q.-D.; Jeldres, C.; Perrotte, P.; Gallina, A.; Tostain, J.; Patard, J.-J. C-Reactive Protein Is an Informative Predictor of Renal Cell Carcinoma-Specific Mortality: A European Study of 313 Patients. Cancer 2007, 110, 1241–1247. [Google Scholar] [CrossRef]
- Kim, D.-K.; Oh, S.Y.; Kwon, H.-C.; Lee, S.; Kwon, K.A.; Kim, B.G.; Kim, S.-G.; Kim, S.-H.; Jang, J.S.; Kim, M.C.; et al. Clinical Significances of Preoperative Serum Interleukin-6 and C-Reactive Protein Level in Operable Gastric Cancer. BMC Cancer 2009, 9, 155. [Google Scholar] [CrossRef] [Green Version]
- Pierce, B.L.; Ballard-Barbash, R.; Bernstein, L.; Baumgartner, R.N.; Neuhouser, M.L.; Wener, M.H.; Baumgartner, K.B.; Gilliland, F.D.; Sorensen, B.E.; McTiernan, A.; et al. Elevated Biomarkers of Inflammation Are Associated with Reduced Survival among Breast Cancer Patients. J. Clin. Oncol. 2009, 27, 3437–3444. [Google Scholar] [CrossRef]
- Scott, H.R.; McMillan, D.C.; Forrest, L.M.; Brown, D.J.F.; McArdle, C.S.; Milroy, R. The Systemic Inflammatory Response, Weight Loss, Performance Status and Survival in Patients with Inoperable Non-Small Cell Lung Cancer. Br. J. Cancer 2002, 87, 264–267. [Google Scholar] [CrossRef]
- Nakamura, T.; Matsumine, A.; Matsubara, T.; Asanuma, K.; Uchida, A.; Sudo, A. Clinical Significance of Pretreatment Serum C-Reactive Protein Level in Soft Tissue Sarcoma. Cancer 2012, 118, 1055–1061. [Google Scholar] [CrossRef]
- Siontis, B.L.; Leja, M.; Chugh, R. Current Clinical Management of Primary Cardiac Sarcoma. Expert Rev. Anticancer 2020, 20, 45–51. [Google Scholar] [CrossRef]
- Ramlawi, B.; Leja, M.J.; Abu Saleh, W.K.; Al Jabbari, O.; Benjamin, R.; Ravi, V.; Shapira, O.M.; Blackmon, S.H.; Bruckner, B.A.; Reardon, M.J. Surgical Treatment of Primary Cardiac Sarcomas: Review of a Single-Institution Experience. Ann. Thorac. Surg. 2016, 101, 698–702. [Google Scholar] [CrossRef] [Green Version]
- Woll, P.J.; Reichardt, P.; Le Cesne, A.; Bonvalot, S.; Azzarelli, A.; Hoekstra, H.J.; Leahy, M.; Van Coevorden, F.; Verweij, J.; Hogendoorn, P.C.W.; et al. Adjuvant Chemotherapy with Doxorubicin, Ifosfamide, and Lenograstim for Resected Soft-Tissue Sarcoma (EORTC 62931): A Multicentre Randomised Controlled Trial. Lancet Oncol. 2012, 13, 1045–1054. [Google Scholar] [CrossRef]
- Patel, S.R.; Gandhi, V.; Jenkins, J.; Papadopolous, N.; Burgess, M.A.; Plager, C.; Plunkett, W.; Benjamin, R.S. Phase II Clinical Investigation of Gemcitabine in Advanced Soft Tissue Sarcomas and Window Evaluation of Dose Rate on Gemcitabine Triphosphate Accumulation. J. Clin. Oncol. 2001, 19, 3483–3489. [Google Scholar] [CrossRef]
- Hensley, M.L.; Maki, R.; Venkatraman, E.; Geller, G.; Lovegren, M.; Aghajanian, C.; Sabbatini, P.; Tong, W.; Barakat, R.; Spriggs, D.R. Gemcitabine and Docetaxel in Patients with Unresectable Leiomyosarcoma: Results of a Phase II Trial. J. Clin. Oncol. 2002, 20, 2824–2831. [Google Scholar] [CrossRef]
- Siontis, B.L.; Zhao, L.; Leja, M.; McHugh, J.B.; Shango, M.M.; Baker, L.H.; Schuetze, S.M.; Chugh, R. Primary Cardiac Sarcoma: A Rare, Aggressive Malignancy with a High Propensity for Brain Metastases. Sarcoma 2019, 2019, 1960593. [Google Scholar] [CrossRef] [Green Version]
- Isambert, N.; Ray-Coquard, I.; Italiano, A.; Rios, M.; Kerbrat, P.; Gauthier, M.; Blouet, A.; Chaigneau, L.; Duffaud, F.; Piperno-Neumann, S.; et al. Primary Cardiac Sarcomas: A Retrospective Study of the French Sarcoma Group. Eur. J. Cancer 2014, 50, 128–136. [Google Scholar] [CrossRef]
- Iwamoto, Y.; Tanaka, K.; Isu, K.; Kawai, A.; Tatezaki, S.; Ishii, T.; Kushida, K.; Beppu, Y.; Usui, M.; Tateishi, A.; et al. Multiinstitutional Phase II Study of Neoadjuvant Chemotherapy for Osteosarcoma (NECO Study) in Japan: NECO-93J and NECO-95J. J. Orthop. Sci. 2009, 14, 397–404. [Google Scholar] [CrossRef]
- Larrier, N.A.; Czito, B.G.; Kirsch, D.G. Radiation Therapy for Soft Tissue Sarcoma: Indications and Controversies for Neoadjuvant Therapy, Adjuvant Therapy, Intraoperative Radiation Therapy, and Brachytherapy. Surg. Oncol. Clin. N. Am. 2016, 25, 841–860. [Google Scholar] [CrossRef]

Publisher’s Note: MDPI stays neutral with regard to jurisdictional claims in published maps and institutional affiliations. |
© 2022 by the authors. Licensee MDPI, Basel, Switzerland. This article is an open access article distributed under the terms and conditions of the Creative Commons Attribution (CC BY) license (https://creativecommons.org/licenses/by/4.0/).
Share and Cite
Stoica, A.I.; Harpa, M.M.; Banceu, C.M.; Ghiragosian, C.; Opris, C.E.; Al-Hussein, H.; Al-Hussein, H.; Flamind Oltean, S.; Mezei, T.; Mares, R.G.; et al. A Rare Case of Undifferentiated Pleomorphic Cardiac Sarcoma with Inflammatory Pattern. Medicina 2022, 58, 1009. https://doi.org/10.3390/medicina58081009
Stoica AI, Harpa MM, Banceu CM, Ghiragosian C, Opris CE, Al-Hussein H, Al-Hussein H, Flamind Oltean S, Mezei T, Mares RG, et al. A Rare Case of Undifferentiated Pleomorphic Cardiac Sarcoma with Inflammatory Pattern. Medicina. 2022; 58(8):1009. https://doi.org/10.3390/medicina58081009
Chicago/Turabian StyleStoica, Alexandra Iulia, Marius Mihai Harpa, Cosmin Marian Banceu, Claudiu Ghiragosian, Carmen Elena Opris, Hussam Al-Hussein, Hamida Al-Hussein, Sanziana Flamind Oltean, Tibor Mezei, Razvan Gheorghita Mares, and et al. 2022. "A Rare Case of Undifferentiated Pleomorphic Cardiac Sarcoma with Inflammatory Pattern" Medicina 58, no. 8: 1009. https://doi.org/10.3390/medicina58081009
APA StyleStoica, A. I., Harpa, M. M., Banceu, C. M., Ghiragosian, C., Opris, C. E., Al-Hussein, H., Al-Hussein, H., Flamind Oltean, S., Mezei, T., Mares, R. G., & Suciu, H. (2022). A Rare Case of Undifferentiated Pleomorphic Cardiac Sarcoma with Inflammatory Pattern. Medicina, 58(8), 1009. https://doi.org/10.3390/medicina58081009






